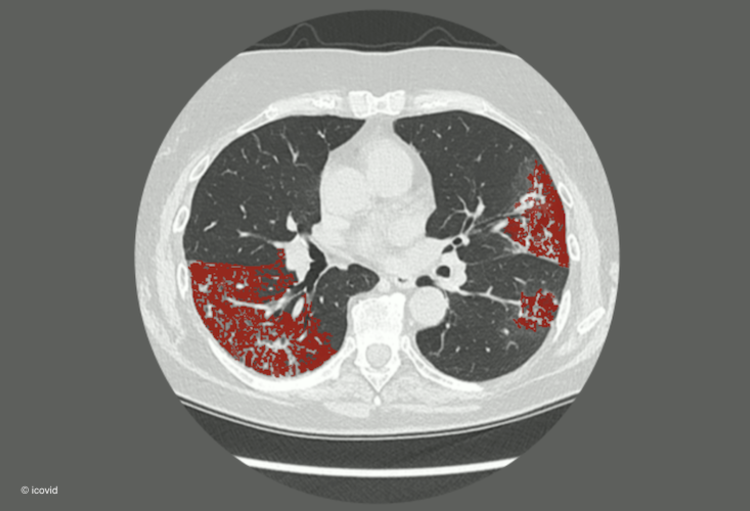

Dankzij het Belgische initiatief "icovid" en haar toepassing "icolung" werd het in onder meer het UZ Brussel mogelijk gemaakt om longscans in te zetten als een triagemiddel voor mensen die besmet zijn met covid-19. De toepassing die werd ontwikkeld door het UZ Brussel, KULeuven, icometrix en ETRO, een imec onderzoeksgroep van de VUB is een succes en wordt daarom uitgerold over heel Europa.
Bij de uitbraak van de coronapandemie in maart werd door de initiatiefnemers van icovid gekeken naar artificiële intelligentie om bij longscans verdachte letsels en dus een mogelijk covid-19-besmetting op te sporen. Het resultaat was de tool icolung, een nieuw triagemiddel.
"Gedurende de drukste periodes werd zelfs iedereen die als patiënt het UZ Brussel binnenkwam gescand, ook als middel om COVID-19-uitbraken in het ziekenhuis te voorkomen", vertelt Johan de Mey, Hoofd van Radiologie UZ Brussel.
De tool icolung wordt vandaag al in 75 ziekenhuizen wereldwijd ingezet. Al 35.000 patiënten werden door de software geanalyseerd, maar het project breidt uit. Dankzij de steun van het EU Horizon 2020 programma wordt de software gratis uitgerold worden in 800 ziekenhuizen in Europa.
Tegelijkertijd biedt de Europese steun de mogelijkheid om binnen het project icovid verder in te zetten op schaalvergroting. De onderzoekers proberen samen met hun partners om ook andere klinische informatie in de modellen te verwerken. Zo moet de verbeterde software toestaan dat ze de vaak nog onbekende langetermijneffecten van covid-19 beter kunnen voorspellen.